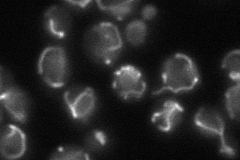
YDL178W

View description
D-lactate dehydrogenase, located in the mitochondrial matrix
Localization:
Intensity:
Fold change:
Significance:
-
C’ GFP library in SD

mitochondria66.2 -
N' NOP1pr-GFP in SD

mitochondria118.284 -
N' TEF2pr-mCherry in SD

mitochondria145.163 -
N' NATIVEpr-GFP in SD
mitochondria60.7467 -
N' TEF2pr-VC and Cyto-VN in SD

#N/A0 -
C’ GFP library in SD+DTT

mitochondria84.741.27No -
C’ GFP library in SD+H2O2

mitochondria71.181.07No -
C’ GFP library in Starvation Media

mitochondria42.90.64No -
C’ GFP library on the background of Pup2-DaMP

mitochondria -
C’ GFP library on the background of CCT mutant

mitochondria71.54581.08048No
